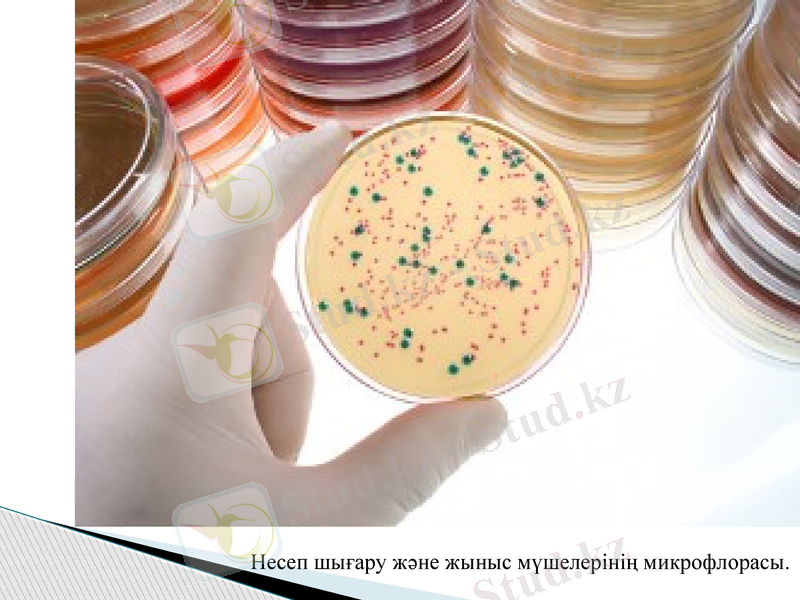
Slide 17

Организм мүшелерінің қалыпты микрофлорасы: биологиялық маңызы және дисбактериоз



ҚАЗАҚСТАН РЕСПУБЛИКАСЫ БІЛІМ және ҒЫЛЫМ МИНИСТРЛІГІ
СЕМЕЙ қаласының ШӘКӘРІМ атындағы МЕМЛЕКЕТТІК УНИВЕРСИТЕТІ
Тақырыбы: Организмнің әрбір ағзаларының қалыпты микрофлорасы. Олардың маңызы. Дисбактериоз.
Орындаған: Кәрімова Е.
Тексерген: Омарбеков Е. О.
Топ: Бл - 309
Семей 2015
БӨЖ №2

Жануар ағзасы микробтардың тіршіілік ету ортасы бола алады. Тері
микрофлорасы тұрақсыз, оның құрамы микроорганизмдердің тіршілік ету жағдайларына, қоршаған ортаға, сонымен қатар жауарлар жанасатын заттарға байланысты. Теріден көбінесе дөңгелек пішінділер: стафилококкалар, диплококкалар, стрептококкалар, сарциналар анықталады. Олар май және тер бездерінің өзекшелерінде тіршілік ете алады және тері зақымданғанда абсцесс, фурункуланың пайда болуына себепші болып, жарақат экссудатының құрамына кіреді.
Таяқша тәріздес бактериялардан ішек таяқшасы, көкірің бактериясы,
пішен бацилласы кездеседі. Теріге топыпақпен кейде көп мөлшерде бациллалар, сондай-ақ зең саңырауқұлақтары мен сәулелі саңырауқұлақтар түседі. Тері жабынының тазалығына байланысты, терінің 1 см2 ауданынан ондаған мыңнан 2 млрд-қа дейінгі микроб жасушалары болады.


Тыныс алу жолдарының микрофлорасы. Тыныс алу жолдарына
микробтар ауаның ең алғашқы порциясымен түседі. Олар жоғарғы тыныс алу жолдарының кілегей қабықтарында орналасады және оның төменгісімен салыстырғанда жоғарғы бөлігінде микроорганизмдер көбірек болады.
Микробтар саны көмекейдің және кеңірдектің кілегей қабығында күрт
азаяды, өкпе паренхимасында мүлдем кездеспейді. Танау қуыстарында негізінен дөңгелек пішінділер мекендейді, ал таяқша тәріздестер сирек кездеседі. Сау жануарлардың танау және көмекей кілегей қабықтарынан стрептококкаларды, тілме таяқшасын және тағы да басқа микробтарды кездестіруге болады.
Тыныс алу жолдарының ішкі бөліміндегі микрофлоралар аз зерттелген.
Адамдарда бұл материалды алудың қиындығымен байланыстырылса, ал жануарларда тыныс алудың ішкі бөлімдеріндегі материалға қол жеткізу оңайырақ.
Ауыз қуысының микрофлорасы сан алуан және ол көбінесе азық
құрамына, жануардың жасына, түріне байланысты. Көпшілік жағдайда дөңгелек пішінділер және таяқша тәріздестер жиі, ал имектелген түрлер сирек кездеседі.

АУЫЗ ҚУЫСЫ

Имектелген бактериялардың ішінен тіс кариесін тудыратын патогенді
емес спирохета кездеседі. Спирохеталар әсіресе жасы ұлғайған ересек шошқалардың ауыз қуысында көп болады. Егер, жемшөпттің ылғалдылығы жоғары болса, онда күйіс қайыратын жануарлардың ауыз қуысындағы микробтар саны да артады.
Бір камералы қарынның асқазан сөлі аздаған микробтар ғана тіршілік
ете алатын қышқылды орта түзетіндіктен микрофлораға өте кедейй боп кедледі. Сүт қышқылды бактериялар, ашытқылар, зең саңырауқұлақтары, бірқатар сарциналар мен бациллалардың қышқылды ортаға төзімділігі жоғарылау. Осындай орталарда қышқылға төзімді бактериялардың шыдамдылығы жақсы.
Асқазан сөлінің секрециясының мөлшері азайған кезде орта
бейтараптанып, шіру микробтарының көбеюіне қолайлы жағдай туады. Претеолитикалық бактериялардың дамуы улы заттардың жинақталуына және ас қорыту процесінің бұзылуына әкеп соғады.

Күйіс қайырушы жануарлардың месқарынының микрофлорасы.
Өмірінің алағашқы күндері және сүтпен қоректену мерзімі барысында күйіс қайырушы жануарлардың месқарынының негізгі микрофлорасы сүт қышқылды бактериялардан тұрады.
Құнарсыз азықтарды қабылдаған кезде микроорганизмдердің өзге де
физиологиялық топтары пайда болады, ал 2-3 айлық жануарларда месқарынның пейзажы сәл де болса тұрақтанады. Месқарын ішіндегі 1мл сұйықтықта 1-10 млрд. Микроб жасушалар кездеседі. Микробтар үлесіне месқарын ішіндегі құрғақ массаныңң 10% тиесілі. Микробтардың физиологиялық топтарының көбеюі немесе азаюына жаңадан түскен азық порциясына байланысты.
Күйіс қайырушы жануарлардың месқарынында микробтардың дамуы
үшін қолайлы жағдай туады: тұрақты температура (37-39С), тұрақты рН (5, 8-7, 3), сілекейдің үздіксіз берілуі (тәулігіне 70л шамасында), ұсақталған азықтың үнемі түсіп отыруы және оның месқарынның жиырылуы нәтижесінде араласуы.

Целлюлозаны ыдыратушы микрообтар. Целлюлоза немесе клетчатка -
ірі азықтардың 20-45% құрайтын негізгі компоненті. Организмге түскен целлюлозаның 90% дейінгісі микробтармен соңғы өнім - глюкозаға ыдыратылып, мал организміне сіңіріледі. Месқарындағы азықтың ашуы нәтижесінде сірке, пропион, май, сонымен қатар валериан және құмырсқа қышқылдары түзіледі.
Целлюлозаның 70% мес қарында, 17% соқыр ішекте, 13% бүйенде
ыдыратылады. Ұлтабар мен аш ішектің бөлімінде клетчатканың ыдырауы жүзеге аспайды, өйткені бұл жерлерде целлюлоза бактерияларының дамуы үшін жағдай қолайсыз болып келеді.
Құрамында азоты бар азықтарды өз протеиндеріне түрлендіретін
бактериялар. Мес қарынның факультативтік-анаэробтық бактерияларының дені жасуша денесін құруға керекті аммиакты және т. б. заттарды ыдыратуға қабілетті болып келеді. Аргинин, гистидин, изолейцин, лейцин, лизин, метионин, фенилаланин, треонин, триптофан, валин сияқты алмастырылмайтын амин қышқылдары синтезделеді. Сондықтан күйіс қайтарушы жануарлар бір камералы асқазанда жануарлармен салыстырғанда алмастыылмайтын амин қышқылдарын азықтан алуға зәру емес.
Мес қарын микробтары аммиактан, көмірқышқыл газынан, күкірттен,
минералдық заттар мен органикалық қышқылдардан амин қышқылдарын синтездеп, денесінің протеиндерін түзеді. Микробтар месқарынның ішіндегі заттармен бірге ұлтабар мен ішекке қарай жылжып, онда ыдырайды да, жануар организмі үшін толық құнды азыққа айналады.

Стрептококкалар мес қарын ішінде көп мөлшерде болады. Олар
крахмалды және глюкозаны сүт қышқылын түзе ыдыратады.
Лактобактериялар кейбір көмірсуларды сүт қышқылын түзе
ыдыратады.
Propionbacterium туысының бактериялары лактатты пропион
қышқылын түзе отырып ыдыртады және В12 дәруменін синтездеуге қатысады.
Бифидобактериялар жасуша ұшы жуандау, түйреуіш тәрізді, түзу
немесе тарамдалған таяқшалар. Олар спора түзбейді, қозғалмайды, Грам тәсілімен оң боялады. Тіршілік ету процесінде сүт, сірке және өзгеде қышқылдарды түзеді, орта реакциясын 4, 0-3, 8-ге дейін төмендетіп, бірқатар шіру және патогенді микробтардың дамуын тежейді. Макроорганизмдер пайдаланатын аминқышқылдары мен көптеген дәрумендерді синтездейді.
Көптеген зерттеушілердің пікірінше, күйіс қайыратын жануарлардың
месқарнында инфузориялардың 120-ға жуық түрі кездеседі, олардың 1 мл сұйықтықтағы жалпы саны 1 миллионнан астам. Месқарындағы қарапайымдылардың барлығы анаэробтарға жатады. Көмірсулық қоректенудің негізгі көзі - еріген қант, ал азоттың көзі шөп сөлі болып саналады.


Мес қарында жануарлардың сүтпен қоректену кезеңінде инфузориялар
болмайды, өйткені мес қарындағы қышқылдық орта оларға қолайсыз әсер етеді. Олардың дамуына құнарсыз азықтар қолайлы жағдай туғызады. Инфузориялар санының артуы малдың құнарсыз азықтармен қоректендіру деңгейіне байланысты. Бұзауларда қарапайымдылар алғашқы 2-3 айлықта дами бастайды, ал олар 1 жасқа жақындағанда қарапайымдылардың мөлшері ересек жануарлардағымен теңеседі. Қозылардың мес қарнында бірен-саран инфузориялар 8-12 күндері пайда болып, 20 күндері оның 1 мл сұйықтықтағы мөлшері 50-60 мыңға дейін артып, 6 айлықта 1 млн-ға жетеді. Қарапайымдылар сыртқы ортада тұрақсыз, бір жануардан келесі жануарға жанасу арқылы және алиментарлық жолмен беріледі. Ашығу кезінде қой мес қарнындағы инфузориялар саны күрт азаяды. Мес қарындағы инфузориялар санына азық құрамы және оның көлемі әсер етеді. Қойлардың қарнындағы инфузориялар саны сиыржоңышқа мен майбұршақтың қоспасын бергенде артады, ал сүрлеммен азықтандырғанда азаяды немесе мүлдем жойылып кетеді.
Азықтандырғаннан бір сағат өткен соң инфузориялардың саны азайып,
бактериялардың көбеюі анықталған, бұл қатынас кейіннен өзгеріске ұшырайды. Мес қарындағы инфузориялар мен бактериялар арасында курделі қарым-қатынас бар, өйткені қарапайымдылар азайғанда бактериялар саны артады немесе керісінше жағдай орын алады. Қарапайымдылардың күйіс қайырушылардың ас қорыту органдарындағы атқаратын рөлі әлі де толық анықталмаған.

Аш ішек бөлімінің микрофлорасы. Он екі елі ішек саңылауына өт өзегі
ашылады. Түскен өт организмдегі микробтарға кері әсерін тигізетіндіктен, он екі елі ішек ішіндегі 1 мл сұйықтықтағы микробтар саны бірнеше мыңнан аспайды. Ішектің тұрақты мекендеушілеріне ішек таяқшасы, энторококтар және кейбір топырақ бациллары жатады.

Тоқ ішек бөлімінің және тік ішек микрофлорасы. Тоқ ішек бөлімі
микробтарға өте бай, олар сондағы құрғақ заттардың 40% -ға дейінгі мөлшерін құрайды. 1 г құрғақ затта 3 млрд-тан астам микроб жасушалары болады. Тоқ ішек бөлімінің тұрақты мекендеушілеріне ішек таяқшасы, энтерококкалар, сүт қышқылды таяқшалар, целлюлоза ыдыратқыш микробтар және бациллалар жатады. Актиномицеттер, ашытқы және зең саңырауқұлақтары сирек кездеседі.
Тоқ ішек бөлімінде азықтың құрамдас бөліктерінің одан әрі ыдырауы
жүзеге асады. Мұнда микроорганизмдердің көптеген физиологиялық топтары үшін қолайлы орта туындайды. Бірақ, осыған қарамастан, микробтар санының артуына кедергі келтіретін көптеген факторлар бар: сүт қышқылды және шіру микробтарының арасындағы антогонизм, өсімдік тектес азықтардағы фитонцидтер әсері және т. б. Сау жануарлардың тоқ ішек бөлімінде кейде сіреспе, бруцеллез, сальмонеллез және басқа да аурулардың қоздырғыштары табылады. Бұны білу мал шаруашылығы қызметкерлері үшін өте маңызды, өйткені көң инфекция көзі болуы әбден ықтимал.
Асқазан-ішек жолының микрофлорасы сан алуан түрлі, тұрақсыз, бірақ
жануарлардың тіршілігі барысында үлкен маңызға ие амин қышқылдарын, дәрумендерді, биологиялық белсенді заттарды түзіп, жалпы ағза мен мүшелердің қызмет етуіне қолайлы әсерін тигізеді. Асқазандағы қалыпты микрофлора қорғаныс функциясын атқарады, табиғи иммунитетті қалыптастырады, өзінің тіршілік әрекеті өнімдерімен бірқатар аурулардың қоздырушыларының дамуын тежейді.


Макроорганизмдегі микробтар популяциясы арасындағы экологиялық
тепе-теңдікті бұзу, антибиотиктік препараттарды дұрыс қолданбау, биоценоздағы организмдер құрамын реттейтін микроб антогонистердің белсенділігін тежеу сияқты әрекеттердің салдарынан асқазанда шартты патогенді микрофлора үшін қолайлы жағдай туындап, нәтижесінде дисбактериоз пайда болады. Жануарлардың резистенттілігі төмендеп, асқазан-ішек жолы аурулары байқала бастайды. Стерильді жағдайда өсірілген микробсыз жануарлардың әдетте ішкі органдарының массасы мен қан сарысуындығы антидене мөлшері төмен және лимфоидтық ұлпасы толық дамымайды, ал бұл өз кезінде организмнің қорғаныс қабілетінің әлсіреп, жұқпалы аураларға ұшырауына әкеледі.
Макроорганизмдегі қалыпты микрофлораның атқаратын рөлі өте зор.
Олар тек қорғаныс күшін арттырып қана қоймай, жануарларды әсіресе күйіс қайырушыларды алмастырмайтын амн қышқылдарымен, дәрумендермен, яғни азық құрамында жеткіліксіз болып табылатын өзге де қоректік заттармен қамтамасыз етеді.
Қалыпты микрофлора - сау адам мен жануарларда кездесетін
микроорганизмдердің ашық биоценозы Аутомикрофлора құрамына макроорганизмге кездейсоқ енген патогенді микроорганизмдер де қосылуы мүмкін.

Несеп шығару және жыныс мүшелерінің микрофлорасы. Жыныс
мүшелерінің кілегей қабықтарында стафилококтарды, стрептококтарды, микрококтарды, дифтероидтарды, қышқылға төзімді микробактерияларды және т. б. микроорганизмдерді кездестіруге болады. Қынаптың тұрақты түрде мекендеушісіне басқа микроорганизмдерге анық байқалатын антогонистік қасиеті бар Bact7 vaginale vulgare-ні жатқызуға болады. Несеп-жыныс жолдарының қалыпты физиологиялық жағдайларында микрофлора тек олардың сыртқы бөліктерінде ғана болады.
Жатыр және қуық физиологиялық жағдайда стерильді немесе
микрофлорадан таза. Несеп-жыныс мүшелерінің әртүрлі аурулары кезінде қынап микрофлорасы өзгереді.
Шетелдік авторлардың мәліметтері бойынша төлдеу жолдарының
кілегейлі қабықтарында шоғырланған микрофлоралар түрі сан алуан болып келеді.
Несеп шығару және жыныс мүшелерінің микрофлорасы.

- Іс жүргізу
- Автоматтандыру, Техника
- Алғашқы әскери дайындық
- Астрономия
- Ауыл шаруашылығы
- Банк ісі
- Бизнесті бағалау
- Биология
- Бухгалтерлік іс
- Валеология
- Ветеринария
- География
- Геология, Геофизика, Геодезия
- Дін
- Ет, сүт, шарап өнімдері
- Жалпы тарих
- Жер кадастрі, Жылжымайтын мүлік
- Журналистика
- Информатика
- Кеден ісі
- Маркетинг
- Математика, Геометрия
- Медицина
- Мемлекеттік басқару
- Менеджмент
- Мұнай, Газ
- Мұрағат ісі
- Мәдениеттану
- ОБЖ (Основы безопасности жизнедеятельности)
- Педагогика
- Полиграфия
- Психология
- Салық
- Саясаттану
- Сақтандыру
- Сертификаттау, стандарттау
- Социология, Демография
- Спорт
- Статистика
- Тілтану, Филология
- Тарихи тұлғалар
- Тау-кен ісі
- Транспорт
- Туризм
- Физика
- Философия
- Халықаралық қатынастар
- Химия
- Экология, Қоршаған ортаны қорғау
- Экономика
- Экономикалық география
- Электротехника
- Қазақстан тарихы
- Қаржы
- Құрылыс
- Құқық, Криминалистика
- Әдебиет
- Өнер, музыка
- Өнеркәсіп, Өндіріс
Қазақ тілінде жазылған рефераттар, курстық жұмыстар, дипломдық жұмыстар бойынша біздің қор #1 болып табылады.



Ақпарат
Қосымша
Email: info@stud.kz